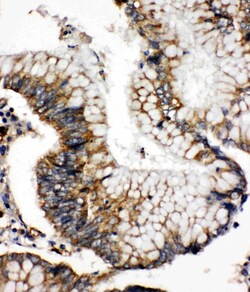
Invitrogen SOD2 (MnSOD) Polyclonal Antibody 100 &mu;g; Unconjugated:Antikörper

missing translation for 'onlineSavingsMsg'
Learn More
Learn More
Invitrogen™ SOD2 (MnSOD) Polyclonal Antibody


Rabbit Polyclonal Antibody
Marke: Invitrogen™ PA580048
Dieser Artikel kann nicht zurückgegeben werden.
Rückgaberichtlinie anzeigen
Beschreibung
Reconstitute with 0.2 mL of distilled water to yield a concentration of 500 μg/mL. Positive Control - WB: human HepG2 whole cell, rat liver tissue, rat lung tissue, mouse liver tissue, mouse lung tissue. IHC: rat brain tissue, human intestinal cancer tissue. ICC/IF: U2OS cells.
Superoxide dismutase (SOD) is an antioxidant enzyme involved in the defense system against reactive oxygen species (ROS). SOD catalyzes the dismutation reaction of superoxide radical anion (O2) to hydrogen peroxide, which is then catalyzed to innocuous O2 and H2O by glutathione peroxidase and catalase. Several classes of SOD have been identified. These include intracellular copper, zinc SOD (Cu, Zn-SOD/SOD-1), mitochondrial manganese SOD (Mn-SOD/SOD-2) and extracellular Cu, Zn-SOD (EC-SOD/SOD-3). SOD1 is found in all eukaryotic species as a homodimeric 32 kDa enzyme containing one each of Cu and Zn ion per subunit. The manganese containing 80 kDa tetrameric enzyme SOD2, is located in the mitochondrial matrix in close proximity to a primary endogenous source of superoxide, the mitochondrial respiratory chain. SOD3 is a heparin-binding multimer of disulfide-linked dimers, primarily expressed in human lungs, vessel walls and airways. SOD4 is a copper chaperone for superoxide dismutase (CCS), which specifically delivers Cu to copper/zinc superoxide dismutase. CCS may activate copper/zinc superoxide dismutase through direct insertion of the Cu cofactor.
Spezifikation
| SOD2 (MnSOD) | |
| Polyclonal | |
| Unconjugated | |
| SOD2 | |
| I79_015272; indophenoloxidase B; IPO B; IPOB; IPO-B; manganese SOD; manganese superoxide dismutase; manganese-containing superoxide dismutase; mangano-superoxide dismutase; manganous superoxide dismutase; mitochondrial superoxide dismutase 2; Mn superoxide dismutase; MNSOD; Mn-SOD; MVCD6; similar to manganous superoxide dismutase; Sod2; Sod-2; sod2.L; sodMt; Superoxide dimutase 2, mitochondrial; superoxide dismutase; superoxide dismutase (Mn type); superoxide dismutase [Mn], mitochondrial; superoxide dismutase 2; superoxide dismutase 2 L homeolog; superoxide dismutase 2, mitochondrial; superoxide dismutase 2, mitochondrial L homeolog | |
| Rabbit | |
| Antigen affinity chromatography | |
| RUO | |
| 20656, 24787, 6648 | |
| -20°C | |
| Lyophilized |
| Immunohistochemistry (Paraffin), Western Blot, Immunocytochemistry | |
| 500 μg/mL | |
| Antibody with 5mg BSA, 0.2mg Na2PO4, 0.9mg NaCl and 0.05mg sodium azide, 0.05mg thimerosal | |
| P04179, P07895, P09671 | |
| SOD2 | |
| A synthetic peptide corresponding to a sequence at the N-terminus of human SOD2 (45-62aa QIMQLHHSKHHAAYVNNL). | |
| 100 μg | |
| Primary | |
| Human, Mouse, Rat | |
| Antibody | |
| IgG |
Berichtigung von Produktinhalten
Bitte geben Sie uns Ihr Feedback zu den Produktinhalten, indem Sie das folgende Formular ausfüllen.
Name des Produkts
Haben Sie Verbesserungsvorschläge?Übermitteln Sie eine inhaltliche Korrektur